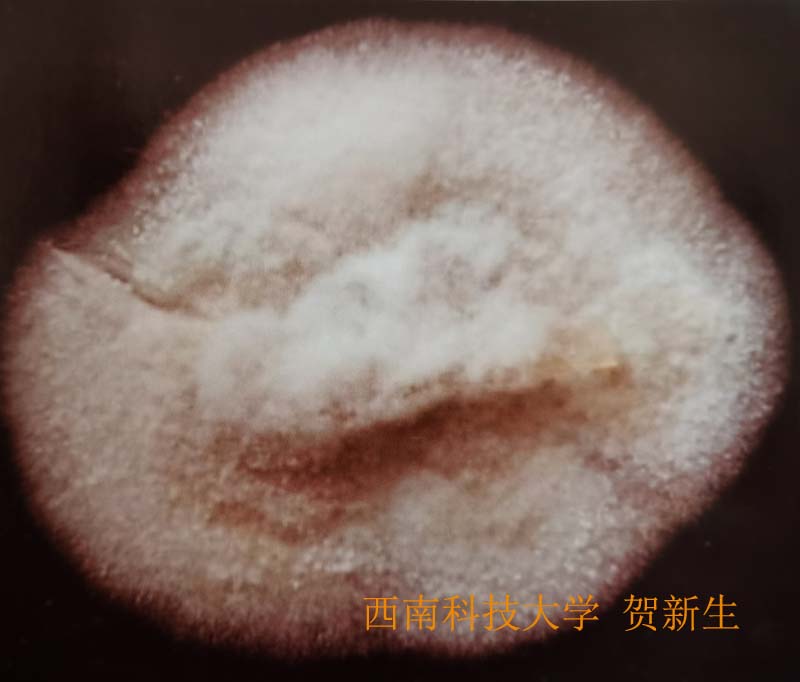

- 盾尖蚁巢伞
- 作者:贺新生 西南科技大学生命科学与农林学院 2025年6月16日 四川绵阳
- 【中文名】 盾尖蚁巢伞
- 【别 名】 盾尖鸡㙡菌、鸡㙡
- 【学 名】 Termitomyces clypeatus R. Heim 1951
- 【生长环境】 夏秋季生于地上,与地下白蚁巢穴相连。
- 【分 布】 我国南方地区。
- 【采集地点】 绵阳市涪城区。
- 【经济价值】 食用菌。味道鲜美。
- 【形态特征】
-
整体形态
-
子实体中型,群生。
-
菌盖
-
菌盖圆形、长椭圆形,(3~9)cmx(3~8)cm,先尖顶伞形,菌盖抱住菌柄、后逐渐开伞平展,中央有一尖而钝的突起,先鼠灰色、灰褐色,褐色,颜色逐渐变淡,后灰白色,尖突部位褐色,光滑,有不明显的辐射状纤丝条纹,老后常撕裂。
-
菌肉
-
菌肉白色,厚2~6mm,伤不变色,香味浓郁,紧实。
-
菌褶
-
菌褶离生,白色,老后淡粉红色,宽3~7mm,很薄,密集菌盖边缘 20~30片/cm,有小菌褶,边缘锯齿状。
-
菌柄
-
菌柄中生,圆柱形,长5~15cm,直径5~13mm稍弯曲,常扭曲,白色,有白色纵条纹,内部菌肉纤丝状,肉质,先实心后空心,基部膨大,直径9~15mm。
-
假根
-
菌柄下部有灰黑色假根,长8~20cm。
-
子实层
-
囊状体腹膨状,中部膨大,(15~65)μmx(5~23.5)μm,无色,透明。菌褶菌髓平行。
-
孢子印淡粉红色。
-
孢子杏仁形、卵圆形,光滑,无色,有一歪尖,内有球状物,非淀粉质,(5~7)μmx(4~5.5)μm。
-
-
菌丝培养
-
管状透明,分枝发达,直径2~5um,无锁状联合。菌丝细胞由长方形逐渐膨大成椭圆形、圆球形,最后形成小白球状。
-
菌丝体紧贴于培养基表面生长,分枝状,渐渐形成绒毛状气生菌丝,先白色,后黄白色,在菌落边缘和中央菌丝渐渐膨大,形成直径100~300um的小白球。生长速度缓慢,1~3mm/d。难培养。

-
【参考文献】
-
1. 贺新生.中国大型真菌物种名录.北京:中国农业出版社.2021
-
2. 贺新生.四川盆地食药用菌图志.北京:科学出版社.2013:260 .
-
3. 李玉,李泰辉,杨祝良 等.中国大型菌物资源图鉴.郑州:中原农民出版社.2015:1040.
-
4. 王向华,刘培贵,于富强.云南野生商品蘑菇图鉴.昆明:云南科技出版社.2004:108 .
欢迎浏览《常见蘑菇索引》,本版为方便手机浏览的简化版,更多蘑菇物种知识请在电脑上浏览,网址:moguyun.vip。





